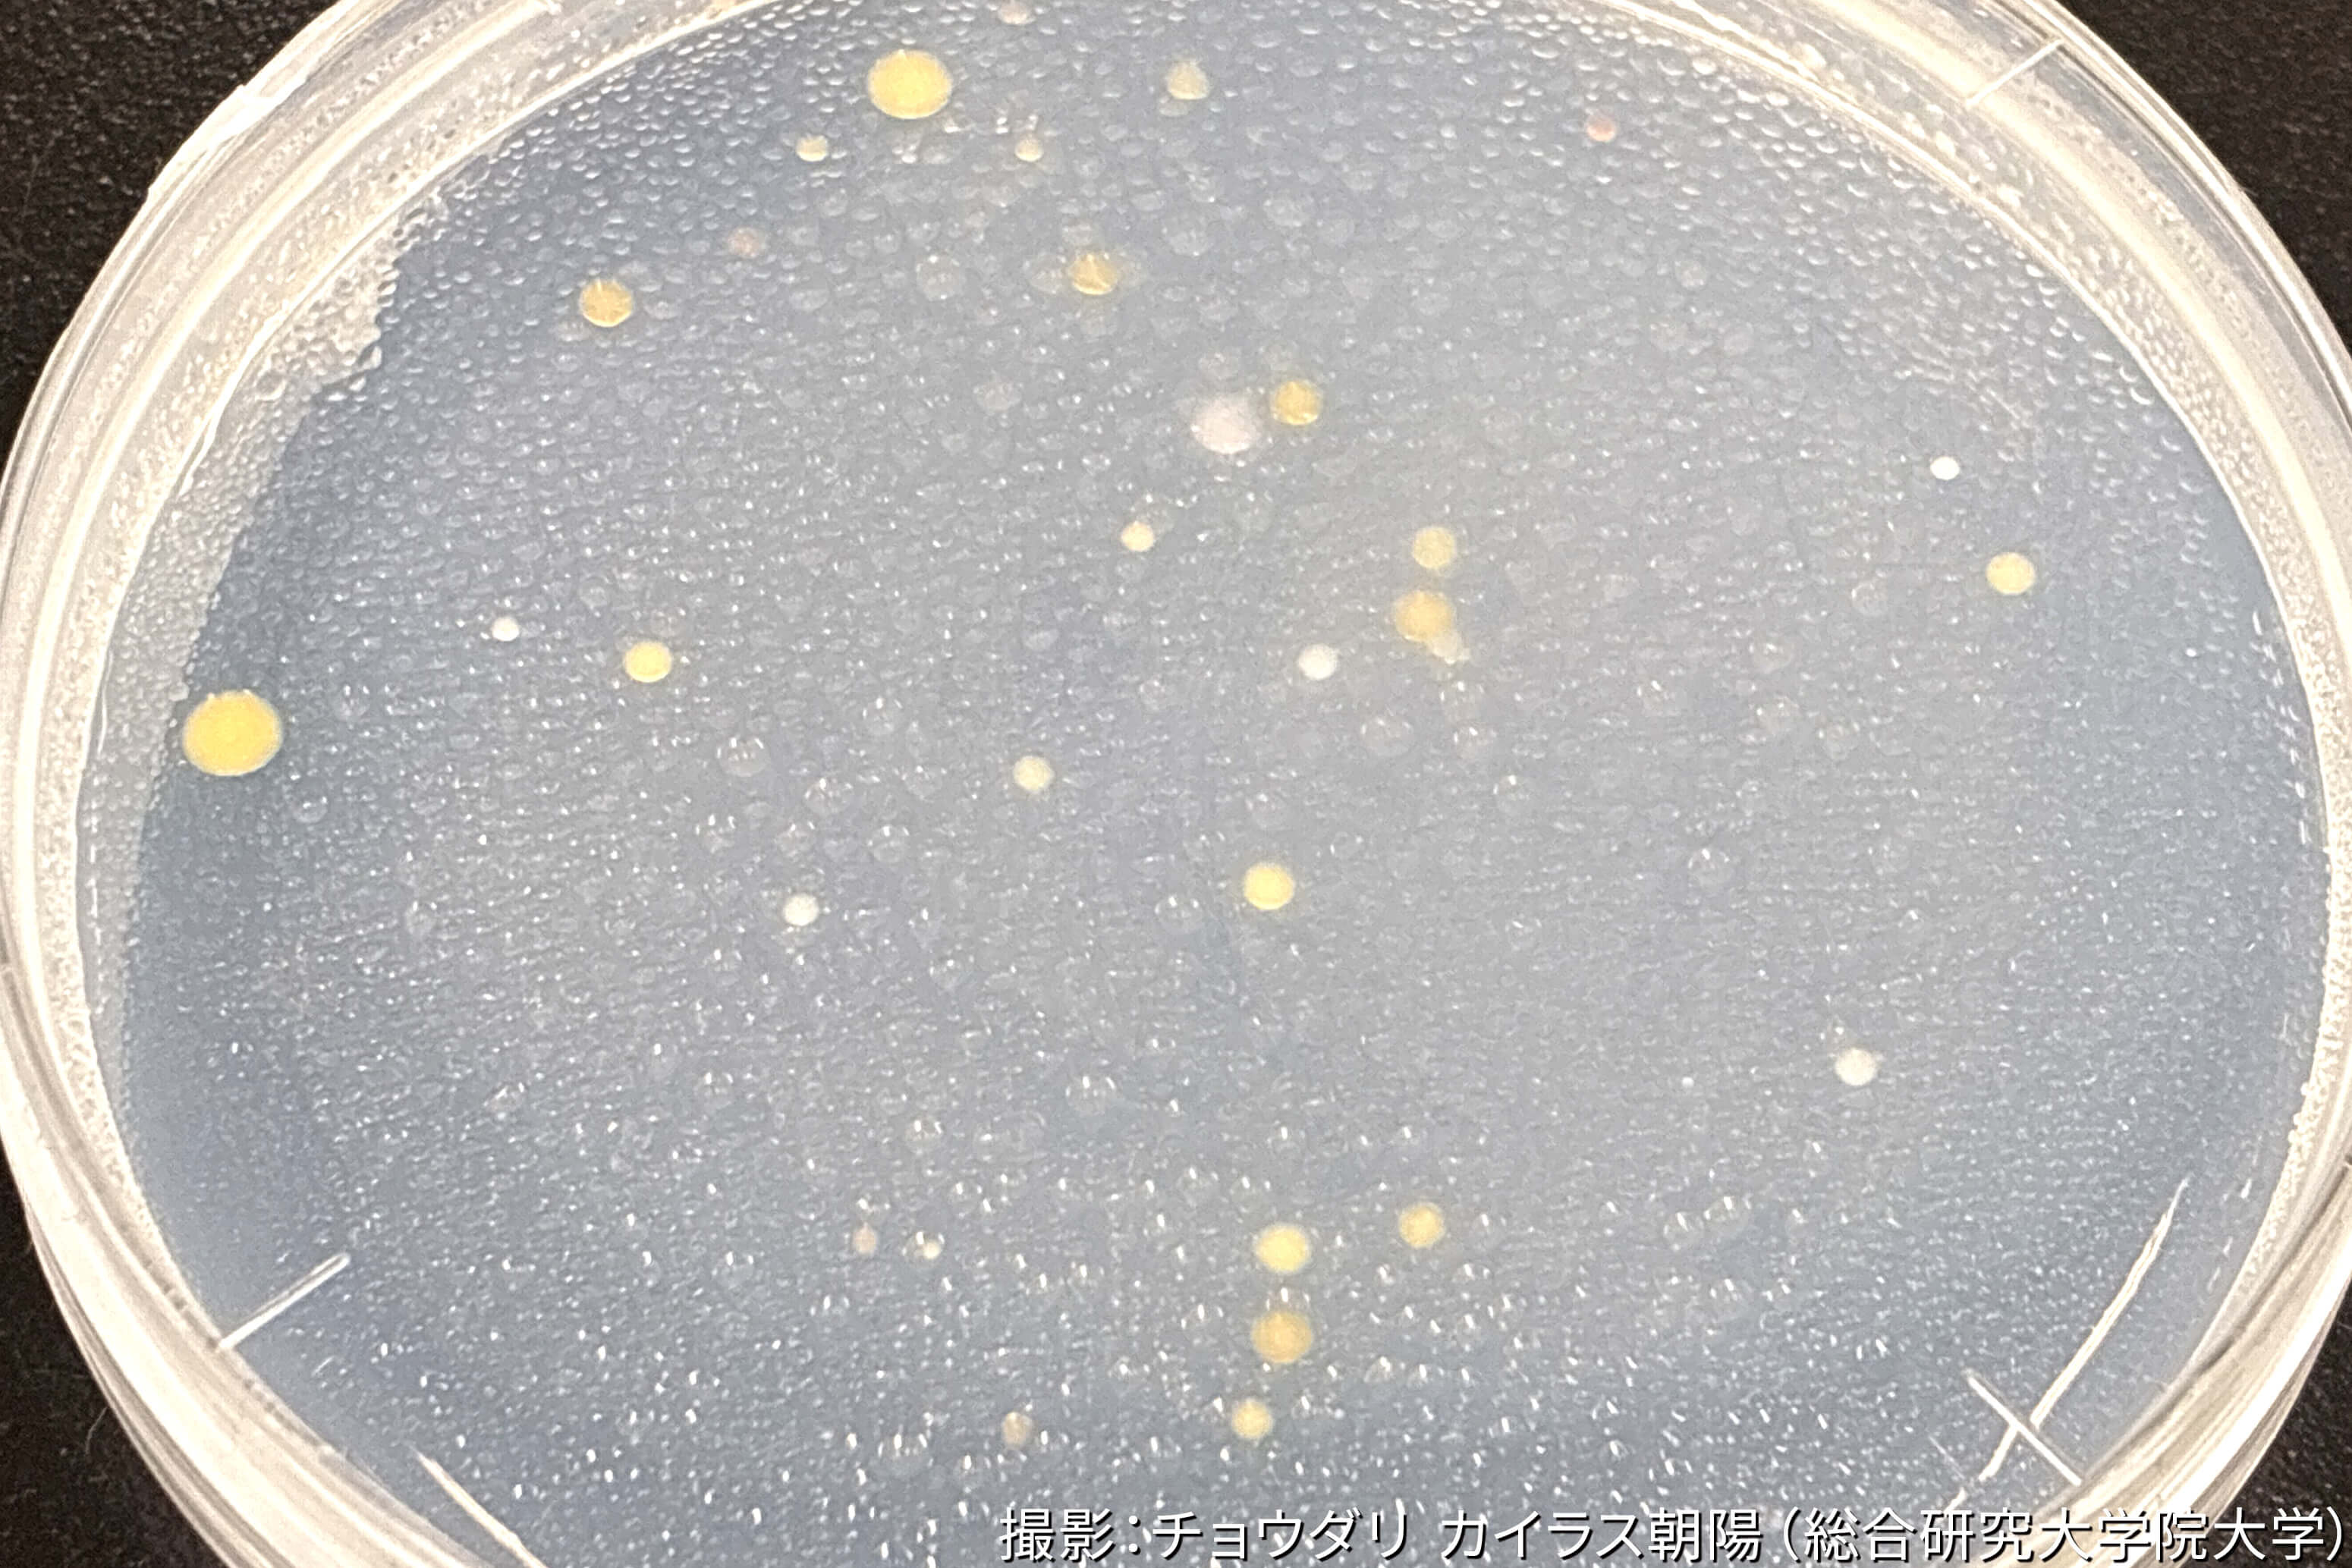

公開日
ノルウェー北極、ブレッガー氷河周辺の微生物調査
投稿日:
執筆者:チョウダリ カイラス朝陽(総合研究大学院大学)
2025年の7月、スバールバル諸島ニーオルスン(ノルウェー)に滞在しました。今回が初めての北極圏滞在です!ニーオルスンにある各国の建物が北欧風で、遠方の山々とのコントラストも相まって素敵でした(写真1)。野外調査では、氷河の麓にあるアウトウォッシュ・プレーン(氷河からの流れる融解水の作用できた地形)に向かいました(写真2)。
アウトウォッシュ・プレーンは北極大気中のダストの主な発生源の1つであると知られていますが、私はその中に含まれる「微生物」に着目しています。空中に舞い上がる微生物の中には、大気中で氷の核となって雲の形成や降水に関与するものが知られています。それらの発生源となる微生物を調査することで、現地の微生物が気象現象に与える役割を研究しています。また、温暖化が急速に進行する北極において、この役割が将来どのように変化していくのかについても研究したいと考えています。
東・西2つのブレッガー氷河、そして、それぞれの氷河末端から下流域のアウトウォッシュ・プレーンにかけて、堆積物のサンプリングを行いました(写真3、4)。氷河へと向かう道なきゴツゴツした岩場や川(氷河の融解水)の迫力が印象的でした(写真5、6)。また、氷河から吹く冷たい風と小雨が降る中、薄いゴム手袋で作業するのは、私にとって極地研究の洗礼となりました。
採取した堆積物試料中の微生物の機能を調査するため、ニーオルスン基地内で培養実験を行いました(写真7)。微生物が増殖すると様々なコロニーが培地上で見え始めます(写真8)。これらの微生物には氷の核となる能力があるのでしょうか?得られたコロニーを一つ一つ単離・培養し、氷晶核(氷の核)としての機能を探っています!
夏、ホッキョクグマの出没数は多く、調査中は常に注意が必要です。氷河周辺での野外活動中にも無線でクマ出没の連絡があり、ニーオルスン基地の近くでも目撃されています。また私が野外調査に同行した際に、崖の上から私たちの目的地方向へと悠々と歩いていくホッキョクグマを見つけました(写真9)!安全を確保するため、速やかに基地へと引き返しましたが、クマの危険性を肌で感じつつも野生の姿を見られた貴重な体験でした。